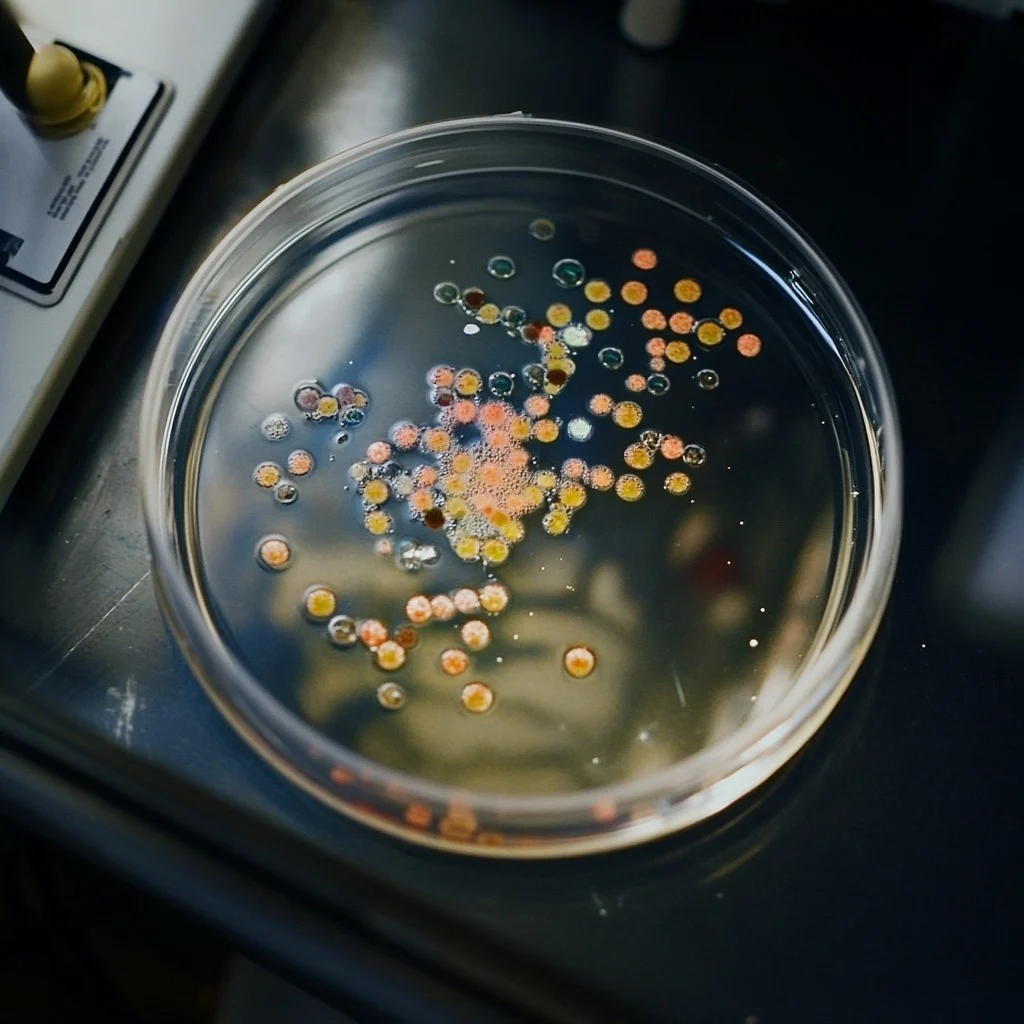
Image

Giải trình tự vi sinh
Giải trình tự vi sinh
Giải trình tự gen thế hệ mới (NGS – Next-Generation Sequencing) là một giải pháp tiên tiến trong vi sinh học, cho phép xác định nhanh chóng và chính xác các loài vi sinh vật trong mẫu sinh học. Phương pháp này được ứng dụng rộng rãi trong y tế, nông nghiệp, môi trường và công nghiệp thực phẩm, đáp ứng nhu cầu phân tích hệ vi sinh vật phức tạp.
NGS hoạt động bằng cách giải trình tự toàn bộ hoặc một phần DNA/RNA của vi sinh vật trong mẫu, chẳng hạn như mẫu đất, nước, máu hoặc thực phẩm. Các kỹ thuật như giải trình tự 16S rRNA (cho vi khuẩn), ITS (cho nấm) hoặc metagenomics (phân tích toàn bộ cộng đồng vi sinh) được sử dụng để xác định loài, chủng và thậm chí các đặc điểm chức năng của vi sinh vật.
An Thịnh mang đến giải pháp cho định danh vi sinh vật, metagenomic, giải trình tự toàn bộ hệ gen vi sinh vật để cung cấp thông tin chi tiết phục vụ chẩn đoán và nghiên cứu. Giải pháp NGS từ An Thịnh cho phép phân tích toàn bộ hệ gen của vi sinh vật, từ vi khuẩn, virus đến nấm, giúp xác định đặc điểm di truyền, sự tiến hóa và các cơ chế gây bệnh
Ưu điểm giải pháp từ An Thịnh
Giải pháp wetlab trọn gói
An Thịnh Biotech tự hào cung cấp trọn gói giải pháp định danh vi sinh từ thiết kế trình tự nhận biết, tách chiết DNA, tạo thư viện và hệ thống giải trình tự đến từ tập đoàn MGI cùng dịch vụ phân tích.
Quy mô linh hoạt
An Thịnh cung cấp nhiều hệ thống tự động thay cho thao tác thủ công như MGISP-NE384 và MGISP-960 và hệ thống giải trình tự thông lượng cao, phù hợp chạy số lượng mẫu lớn theo nhu cầu

Liên hệ
- Số 3 ngõ 1, Lê Văn Thiêm, Phường Thanh Xuân, Thành phố Hà Nội, Việt Nam
- 0989546270
- info@anthinhbiotech.com.vn
